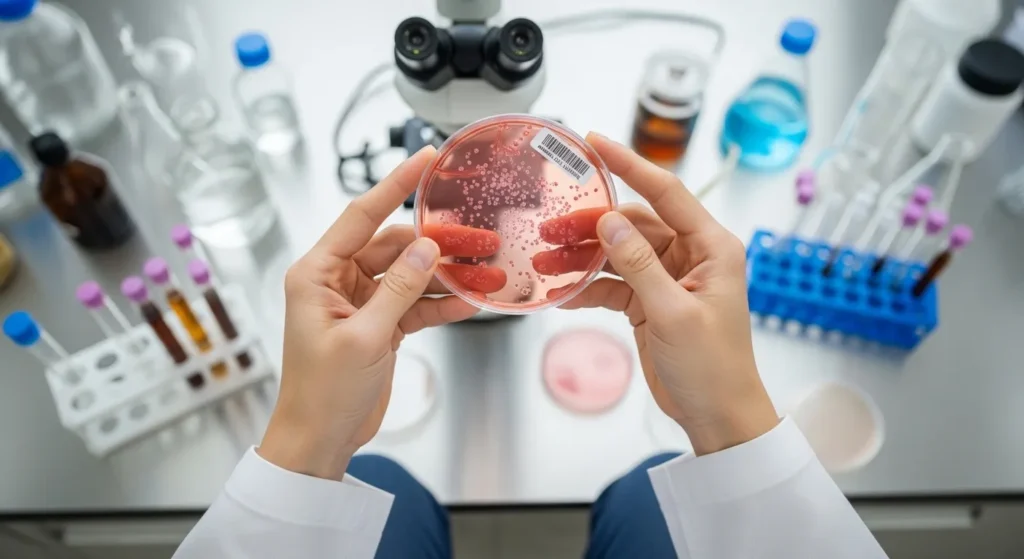
동물세포

전도금 뜻부터 회계처리 정산까지, 자금 관리 사고 막는 실무 전문가의 완벽 가이드
지방 지점이나 현장을 운영하다 보면 본사에서 내려오는 운영비, 즉 ‘전도금’ 관리에 골머리를 앓는 경우가 많습니다. “개인 계좌로 받아도 될까?”, “증빙은 ...

폴리프로필렌(PP) 완벽 가이드: 환경호르몬, 전자레인지 사용, 녹는점 재활용까지 전문가가 밝히는 모든 것
일상생활에서 매일 마주치는 반찬통, 배달 용기, 그리고 무인양품의 깔끔한 수납장까지. 우리는 수많은 플라스틱 속에 살고 있지만, 정작 이것이 뜨거운 물에 ...

기가노토사우루스 완벽 가이드: 티라노를 압도하는 크기와 치악력의 비밀부터 피규어 선택 팁까지
공룡에 열광하는 아이를 둔 부모님이나 고생물학에 갓 입문한 초보자라면 “세상에서 가장 큰 육식 공룡은 무엇일까?”라는 질문을 한 번쯤 마주하게 됩니다. ...
동물세포 구조와 식물세포 차이점 완벽 가이드: 실험 레포트부터 배양 기술까지 총정리
현대 생명공학의 발전 속에서 세포에 대한 이해는 단순한 학술적 지식을 넘어 신약 개발, 재생 의학, 그리고 바이오 산업의 핵심 자산이 ...

아티반정 1mg 효과와 부작용 수면 장애 활용법: 전문가가 알려주는 안전 복용 완벽 가이드
불안과 불면증으로 밤잠을 설칠 때 처방받는 ‘아티반정 1mg’은 단순한 수면제가 아닙니다. 이 약물이 뇌 속에서 어떻게 작용하는지, 그리고 왜 정해진 ...

코대원에스시럽 복용법부터 성분·부작용까지, 목감기 기침 멈추는 완벽 가이드
갑작스러운 기온 변화나 미세먼지로 인해 터져 나오는 기침 때문에 밤잠을 설친 적 있으신가요? 단순한 감기인 줄 알았는데 인후통과 가래가 가라앉지 ...

관동팔경의 으뜸, 강원도 통천군 총석정 위치와 역사적 가치 완벽 가이드
북한 지역의 명승지를 직접 가보지 못하는 아쉬움 속에서, 지리적 위치와 역사적 배경을 정확히 아는 것은 우리 민족의 문화 유산을 이해하는 ...

신궁 완벽 가이드: 미사일 제원부터 메이플 신궁 코강·스킬트리까지 모르면 손해 보는 핵심 정보 총정리
현대 무기 체계에서의 신궁 미사일 도입이나 게임 속 신궁 캐릭터의 최적화 문제로 고민하고 계신가요? 이 글은 방위산업 현장의 기술적 통찰과 ...

구의 부피 공식부터 증명까지, 수학적 직관을 깨우는 입체도형 완벽 가이드
수학 문제를 풀다 보면 구의 부피 공식을 암기했지만, 왜 반지름의 세제곱에 4/3와 π를 곱해야 하는지 의문이 생긴 적 없으셨나요? 이 ...